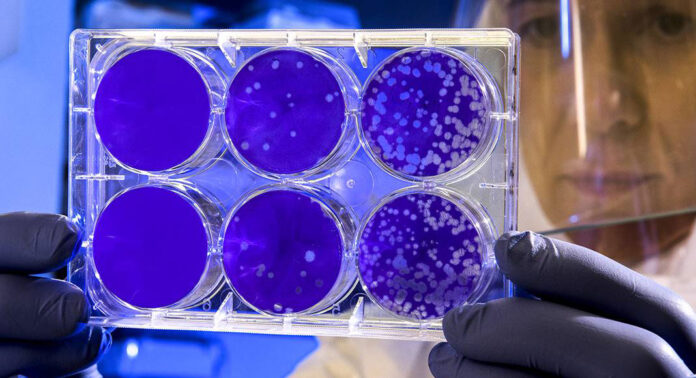

Jorge Heras / Lindero Norte/
MEXICALI,BAJA CALIFORNIA, 25 mayo 2021/
La Secretaría de Salud del Estado reveló que en Mexicali, considerado actualmente el municipio epicentro de la pandemia en la entidad, se han detectado las cinco variantes genéticas de la COVID-19, las cuales son consideradas como más rapido de contagio y más peligrosas.
En su informe médico mañanero, el secretario de Salud, Alonso Pérez Rico dio a conocer que dos de las variantes ya habían sido detctados con anterioridad desde la segunda ola de contagios en enero: las de originen de California B1 427 y la B1 429.
Pero, preocupa al sector salud las registradas durante este mes, porque fueron identificadas por la UABC, el Instituto de Diagnóstico y Referencia Epidemiológica (INDRE), el Sector Público Médico del Condado de Imperial y el Naval Health Research Center, una muerte por la cepa de Reino Unido y el mismo día un contagio de la variante de Brasil.
Un caso más se presentó en el Valle de Mexicali de la variante de Sudáfrica B1 351, quien no contaba con antecedente de viaje, por lo que se trata de un contagio local.
«Mexicali tiene las cinco variantes más peligrosas del mundo en su territorio; la población se tiene que cuidar más, porque las variantes van a transitar por todo el estado, y lo que estamos pidiendo es ʻcomprar tiempoʻ para poder vacunar a más personas», expuso Pérez Rico.
Mexicali escala al sitio ocho en lista de municipios más contagiados de México
Mexicali escaló al peldaño número ocho en la lista nacional de los municipios más contagiosos de Covid-19 en Baja California, debido a que sus casos activos siguen en ascenso, reveló el titular de la Secretaría de Salud, Alonso Pérez Rico.
“Desafortunadamente Mexicali sube del nueve al ocho en la lista nacional de los municipios más contagiosos, vemos que Mexicali gana casos activo, se va a 285, el estado en general ganó casos, tiene 378 casos activos”, mencionó Pérez.